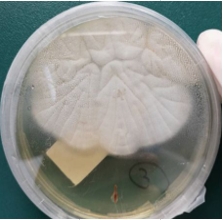
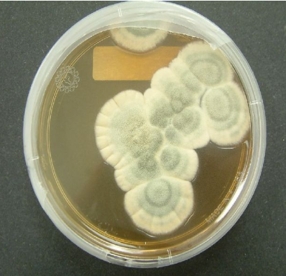
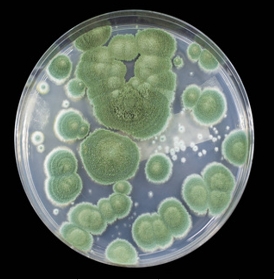
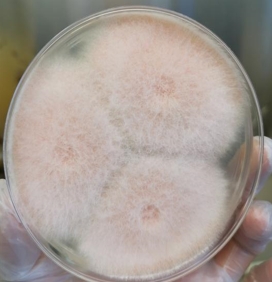
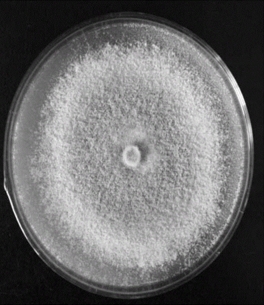

Knowledge Base
Identifying and Assessing Mold
What are the common types of mold
Molds are fungi widely found in nature, with common species including Aspergillus, Penicillium, Trichoderma, Rhizoctonia, Mucor, Fusarium, and others. They reproduce through spores and often grow in moist, organic-rich environments, and may be involved in ecological cycles as well as cause food spoilage or human disease.
I. Common mold classification and characteristics
Aspergillus genus (Aspergillus)
Aspergillus flavus: common in grains, nuts, may produce strong carcinogens aflatoxins.

Aspergillus niger: used in industrial fermentation (e.g. citric acid production), but the immunocompromised people may cause infection.

Aspergillus fumigatus: grows easily in soil, decaying plants and can cause lung infections (aspergillosis).
Penicillium genus (Penicillium)
Penicillium producer: an important strain for the extraction of penicillin, widely used in the production of antibiotics.
Penicillium oryzae: commonly found in rotting parts of citrus fruits, may produce penicillin oryzae (damages kidneys).
Trichoderma (Mucor) and Rhizopus (Rhizopus)
Trichoderma: mostly used in traditional fermented foods (e.g., fermented bean curd, tempeh), strong ability to break down proteins.
Rhizopus: outstanding starch hydrolysis ability, commonly used in the production of wine, sweet rice wine.

Wood mold genus (Trichoderma)
Decomposition of cellulose ability, can be used for bio-fertilizer production; some strains have inhibitory effect on plant pathogenic bacteria.
Fusarium (Fusarium)
Produces erythromycotoxin when contaminating grains, which may cause vomiting, diarrhea, or immune system abnormalities in humans
